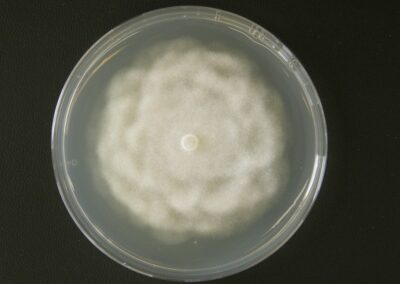

Česká sbírka fytopatogenních oomycetů
Česká sbírka fytopatogenních oomycetů (ČSFO) byla založena v r. 2005 v rámci výzkumného záměru, od r. 2012 je součástí Národního programu konzervace a využívání genetických zdrojů mikroorganismů a drobných živočichů hospodářského významu (NPGZM).
Sbírka se soustřeďuje na uchování genetických zdrojů významných fytopatogenních oomycetů především z území České republiky, zejména pak na aktuální hrozby – na druhy recentně pronikající na území ČR, které mají zároveň potenciál uniknout do volné přírody. Sbírka slouží jako podpora pro výzkum těchto organismů (testy patogenity a rezistence, testování a vývoj metod ochrany, srovnávací materiál pro SRS a jiné instituce, taxonomie, studijní účely, aj.).
V současné době je ve veřejné části sbírky uloženo přes 660 kmenů 60 taxonů oomycetů náležejících do rodů Phytophthora de Bary 1876 (36 taxonů) a Pythium sensu lato (24 taxonů), který je rozdělen do rodů Elongisporangium Uzuhashi, Tojo & Kakish. 2010, Globisporangium Uzuhashi, Tojo & Kakish. 2010, Phytopythium Abad, De Cock, Bala, Robideau, A.M. Lodhi & Lévesque 2010 a Pythium Pringsh. 1858 sensu stricto.
Izoláty byly získány z mnoha desítek různých taxonů hostitelů – zejména lesních, okrasných a ovocných dřevin a z dalších hostitelů a z nejrůznějších typů porostů a výsadeb v rámci celé ČR (městské parky, soukromé zahrady, břehové a lesní porosty, okrasné školky, sady, zahradnické prodejny). V pracovní části sbírky je uloženo více než 500 dalších kmenů.
Personál sbírky tvoří Mgr. Markéta Hrabětová (kurátor), Ing. Marcela Mrázková (zástupce kurátora) a Mgr. Liliya Fedusiv (technik).
Pracovníci sbírky
Přehled uložených taxonů k 31. 1. 2023
Phytophthora alni subsp. alni C.M. Brasier & S.A. Kirk
Phytophthora alni subsp. uniformis C.M. Brasier & S.A. Kirk
Phytophthora bilorbang Aghighi & T.I. Burgess
Phytophthora cactorum (Lebert & Cohn) J. Schröt.
Phytophthora cambivora (Petri) Buisman
Phytophthora cinnamomi Rands
Phytophthora citrophthora (R.E. & E.H. Smith) Leonian
Phytophthora cryptogea Pethybridge & Lafferty
Phytophthora gallica T. Jung & J. Nechwatal
Phytophthora gonapodyides (H.E. Petersen) Buisman
Phytophthora gregata T. Jung, Stukely & T.I. Burgess
Phytophthora hedraiandra De Cock & Man in ‚t Veld
Phytophthora chlamydospora Brasier & E.M. Hansen
Phytophthora chlamydospora x amnicola
Phytophthora inundata Brasier, Sánch. Hern. & S.A. Kirk
Phytophthora lacustris Brasier, Cacciola, Nechwatal, Jung & Bakonyi
Phytophthora megasperma Drechsler
Phytophthora multibullata Q.N. Dang & T.I. Burgess
Phytophthora multivora P.M. Scott & T. Jung
Phytophthora nicotianae Breda de Haan
Phytophthora niederhauseri Z.G. Abad & J.A. Abad
Phytophthora occultans Man in ’t Veld & Rosendahl
Phytophthora palmivora E. J. Butler
Phytophthora pini Leonian
Phytophthora plurivora T. Jung & T.I. Burgess
Phytophthora polonica Belbahri, E. Moralejo, Calmin & Oszako
Phytophthora pseudocryptogea Safaief., Mostowf., G.E. Hardy & T.I. Burgess
Phytophthora pseudosyringae T. Jung & Delatour
Phytophthora ramorum Werres, De Cock & Man in ‚t Veld
Phytophthora rosacearum (H.E. Petersen) Buisman
Phytophthora rubi (W.F. Wilcox & J.M. Duncan) Man in ‚t Veld
Phytophthora sansomeana E.M. Hansen & Reeser
Phytophthora x stagnum
Phytophthora syringae (Kleb.) Kleb.
Phytophthora taxon Raspberry
Phytophthora taxon Walnut
Elongisporangium anandrum (Drechsler) Uzuhasi, Tojo & Kakish.
Elongisporangium dimorphum (F.F. Hendrix & W.A. Campb.) Uzuhasi, Tojo & Kakish.
Elongisporangium helicandrum (Drechsler) Uzuhasi, Tojo & Kakish.
Elongisporangium undulatum (H.E. Petersen) Uzuhasi, Tojo & Kakish.
Globisporangium cylindrosporum (B. Paul) Uzuhashi, Tojo & Kakish.
Globisporangium heterothallicum (W.A. Campb. & F.F. Hendrix) Uzuhashi, Tojo & Kakish.
Globisporangium intermedium (de Bary) Uzuhashi, Tojo & Kakish.
Globisporangium irregulare (Buisman) Uzuhashi, Tojo & Kakish.
Globisporangium macrosporum (Vaartaja & Plaäts-Nit.) Uzuhashi, Tojo & Kakish.
Globisporangium mamillatum (Meurs) Uzuhashi, Tojo & Kakish.
Globisporangium spiculum (B. Paul) Uzuhashi, Tojo & Kakish.
Globisporangium ultimum (Trow) Uzuhashi, Tojo & Kakish.
Phytopythium chamaehyphon (Sideris) Abad, de Cock, Bala, Robideau, Lodhi & Lévesque
Phytopythium citrinum (B. Paul) Abad, de Cock, Bala, Robideau, Lodhi & Lévesque
Phytopythium helicoides (Drechsler) Abad, de Cock, Bala, Robideau, Lodhi & Lévesque
Phytopythium litorale (Nechw.) Abad, de Cock, Bala, Robideau, Lodhi & Lévesque
Phytopythium mercuriale (Belbahri, B. Paul & Lefort) Abad, de Cock, Bala, Robideau, A.M. Lodhi & Lévesque
Phytopythium vexans (de Bary) Abad, de Cock, Bala, Robideau, Lodhi & Lévesque
Pythium conidiophorum Jokl
Pythium dissimile Vaartaja
Pythium emineosum Bala, de Cock & Lévesque
Pythium folliculosum B. Paul
Pythium oopapillum Bala & Lévesque
Pythium pachycaule Ali-Shtayeh
Kompletní katalog – fytopatogenní oomycety, 31. 1. 2023, VÚKOZ
Objednávkový formulář
Izoláty lze také vyhledat v průběžně aktualizované databázi sbírek NPGZM.